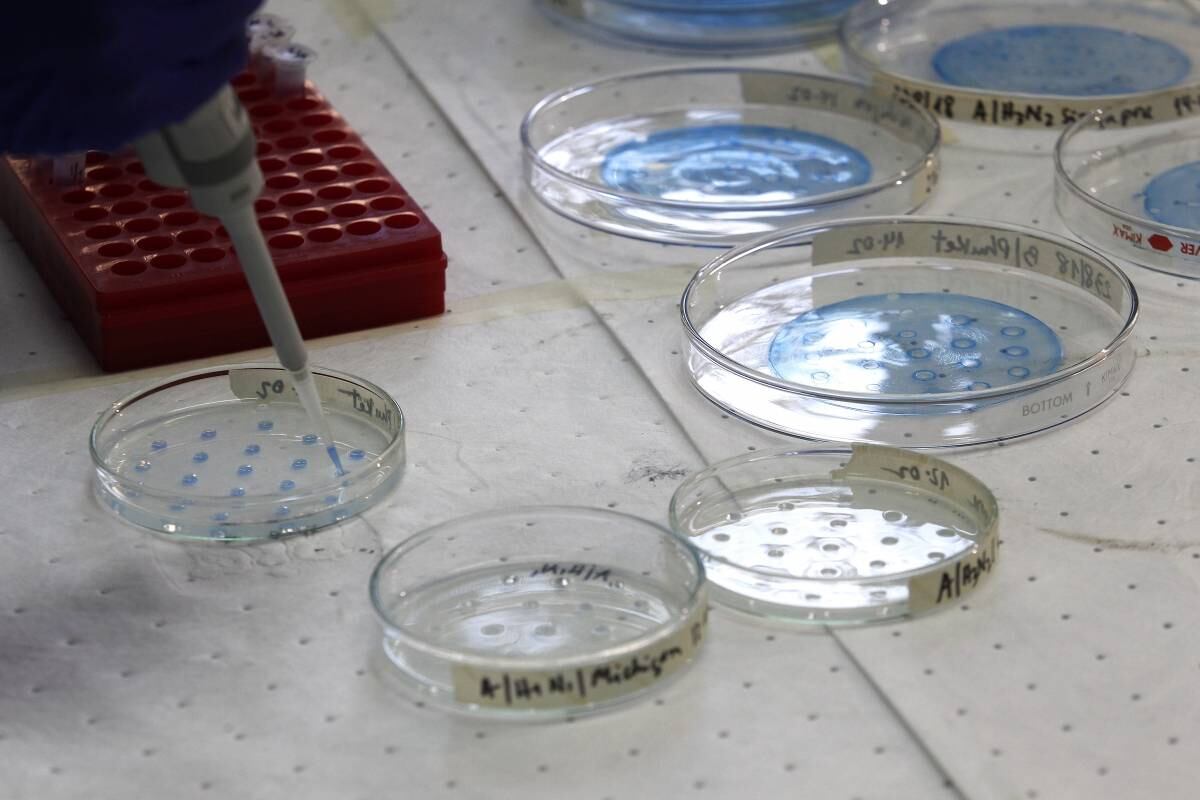

El Ministerio de Salud reportó hoy 6.604 contagios nuevos de covid-19, acercándose al peak alcanzado en junio de 2020, cuando el domingo 14 se registraron 6.938 contagios. Del total informado hoy, 4.482 presentaron síntomas, 1.774 fueron catalogados como asintomáticos y 348 no fueron notificados.
La cifra total de personas que han sido diagnosticadas con coronavirus en el país alcanza a las 918.053, de los cuales 36.433 pacientes se encuentran en etapa activa y la cantidad de recuperados ascendió a 859.097.
En cuanto a los decesos, el DEIS informó que en las últimas 24 horas se registraron 99 fallecidos por causas asociadas al coronavirus, totalizando 22.087 desde el inicio de la pandemia en el país.
Respecto a la de red de laboratorios y la capacidad diagnóstica, ayer se informaron los resultados de 73.129 exámenes PCR, alcanzando a la fecha un total de 10.416.402 test analizados en el país. La positividad a nivel nacional fue de 8,84%.
A la fecha, 2.193 personas se encuentran hospitalizadas en unidades de cuidados intensivos, de las cuales 1.907 están con apoyo de ventilación mecánica. Con relación a la red integrada de salud, existe un total de 201 camas críticas disponibles.
Finalmente, el número de residencias sanitarias disponibles es de 174 con 12.775 cupos. Al día de hoy cuentan con 6.931 usuarios considerando todas las regiones del país.